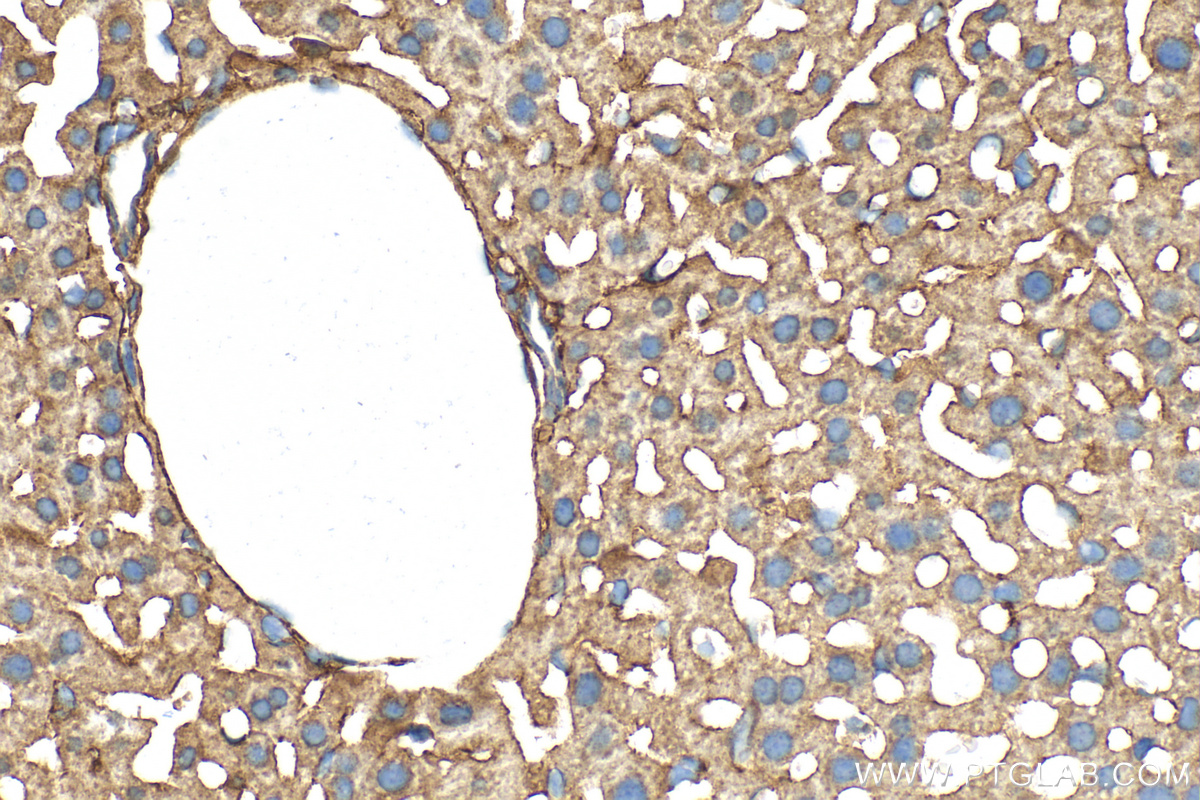

验证数据展示
经过测试的应用
| Positive WB detected in | HeLa cells, PC-12 cells, C6 cells, mouse liver tissue, rat liver tissue |
| Positive IHC detected in | human appendicitis tissue, mouse liver tissue, human urothelial carcinoma tissue Note: suggested antigen retrieval with TE buffer pH 9.0; (*) Alternatively, antigen retrieval may be performed with citrate buffer pH 6.0 |
| Positive IF/ICC detected in | HepG2 cells |
推荐稀释比
| 应用 | 推荐稀释比 |
|---|---|
| Western Blot (WB) | WB : 1:1000-1:2000 |
| Immunohistochemistry (IHC) | IHC : 1:500-1:2000 |
| Immunofluorescence (IF)/ICC | IF/ICC : 1:200-1:800 |
| It is recommended that this reagent should be titrated in each testing system to obtain optimal results. | |
| Sample-dependent, Check data in validation data gallery. | |
产品信息
28478-1-AP targets STEAP3 in WB, IHC, IF/ICC, ELISA applications and shows reactivity with Human, mouse, rat samples.
| 经测试应用 | WB, IHC, IF/ICC, ELISA Application Description |
| 文献引用应用 | WB, IHC, IF |
| 经测试反应性 | Human, mouse, rat |
| 文献引用反应性 | human, mouse, rat, pig, bovine |
| 免疫原 |
CatNo: Ag29528 Product name: Recombinant human STEAP3 protein Source: e coli.-derived, PGEX-4T Tag: GST Domain: 60-130 aa of BC042150 Sequence: NPKRTARLFPSAAQVTFQEEAVSSPEVIFVAVFREHYSSLCSLSDQLAGKILVDVSNPTEQEHLQHRESNA 种属同源性预测 |
| 宿主/亚型 | Rabbit / IgG |
| 抗体类别 | Polyclonal |
| 产品类型 | Antibody |
| 全称 | STEAP family member 3 |
| 别名 | dudlin 2, Dudulin 2, hpHyde, hTSAP6, Metalloreductase STEAP3, pHyde, STEAP family member 3, STEAP3, STMP3, TSAP6 |
| 计算分子量 | 488 aa, 55 kDa |
| 观测分子量 | 45-50 kDa |
| GenBank蛋白编号 | BC042150 |
| 基因名称 | STEAP3 |
| Gene ID (NCBI) | 55240 |
| RRID | AB_3086055 |
| 偶联类型 | Unconjugated |
| 形式 | Liquid |
| 纯化方式 | Antigen affinity purification |
| UNIPROT ID | Q658P3 |
| 储存缓冲液 | PBS with 0.02% sodium azide and 50% glycerol, pH 7.3. |
| 储存条件 | Store at -20°C. Stable for one year after shipment. Aliquoting is unnecessary for -20oC storage. |
背景介绍
STEAP3 (Six-Transmembrane Epithelial Antigen of Prostate 3) is also named as TSAP6, Dudulin-2 and pHyde, and belongs to the STEAP family. STEAP3 is a member of the STEAP family and is composed of a six-transmembrane domain at the COOH-terminal domain and a cytoplasmic N-terminal oxidoreductase domain, which is essential for iron and copper uptake (PMID:16227996). STEAP3 contains a functional p53-binding site in its promoter and can be upregulated following p53 activation to enhance cell death in myeloid leukemia cell line and breast cancer cells (PMID: 18617898). By interacting with Nix, a pro-apoptotic Bcl-2 family member, and Myt1 kinase, a negative regulator of the G2/M transition, STEAP3 overexpression promotes apoptosis and inhibits G2/M transition in cell cycle progression (PMID: 12606722, PMID: 10504341).
实验方案
| Product Specific Protocols | |
|---|---|
| IF protocol for STEAP3 antibody 28478-1-AP | Download protocol |
| IHC protocol for STEAP3 antibody 28478-1-AP | Download protocol |
| WB protocol for STEAP3 antibody 28478-1-AP | Download protocol |
| Standard Protocols | |
|---|---|
| Click here to view our Standard Protocols |
发表文章
| Species | Application | Title |
|---|---|---|
FASEB J Prolonged tamoxifen treatment induces iron deposition and ferroptosis in the liver | ||
BMC Pulm Med PCR array analysis reveals a novel expression profile of ferroptosis-related genes in idiopathic pulmonary fibrosis | ||
Int Immunopharmacol STEAP3-SLC39A8-mediated microglia ferroptosis involved in neurotoxicity in rats after exposure to lead and cadmium combined | ||
J Dairy Sci Heat shock protein B1-mediated ferroptosis regulates mitochondrial dysfunction in adipose tissue of ketotic dairy cows | ||
Cells The Six-Transmembrane Epithelial Antigen of the Prostate (STEAP) 3 Regulates the Myogenic Differentiation of Yunan Black Pig Muscle Satellite Cells (MuSCs) In Vitro via Iron Homeostasis and the PI3K/AKT Pathway | ||
Biol Direct TFAP2C-mediated transcriptional activation of STEAP3 promotes lung squamous cell carcinoma progression by regulating the β-catenin pathway |